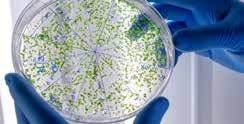

Nova microbiota

Entenda o que são as bactérias resistentes encontradas na bacia do Rio Paraopeba
CIÊNCIAS 10
Vá ao teatro
Até 12 de fevereiro, campanha de popularização oferece peças a preços acessíveis
CULTURA 11
MG
20 ANOS DE COMUNICAÇÃO
POPULAR
Lançado em 25 de janeiro de 2003, o Brasil de Fato nasce com o objetivo de construir uma visão popular das notícias do Brasil e do mundo. O que era antes um jornal impresso nacional se transformou em tabloides regionais, em programas de rádio, em conteúdo multimídia para as redes sociais e em matérias para o site, com tradução para o inglês e espanhol. Frente à batalha de ideias, seguimos ao lado das trabalhadoras e trabalhadores do Brasil

I REPORTAGEM ESPECIAL 6 E 7
YANOMAMIS:
UMA CRISE PROVOCADA
Ações e omissões generalizadas do governo Bolsonaro se espalharam por Funai, Ibama, Exército e Secretaria Especial de Saúde Indígena, segundo o Ministério Público Federal. O ex-presidente ignorou de maneira proposital e sistemática a crise humanitária provocada pelo garimpo ilegal.

A inação persistiu mesmo após reiteradas decisões judiciais que obrigavam o poder público a agir. Relembre os ataques de Bolsonaro aos povos indígenas desde quando era deputado.
I BRASIL 8

Ricardo Laf /PBH Freepick
Minas Gerais Belo Horizonte, 27 de janeiro a 2 de fevereiro de 2023 • edição 406 • brasildefatomg.com.br • distribuição gratuita
Ricardo Stuckert
Reprodução / Levante Popular da Juventude
ESPAÇO DOS LEITORES
“Pior governador do Brasil!”
Claudia Pereira, sobre a matéria “Para lideranças, Zema usa recurso do acordo em projetos que não interessam aos atingidos”
“É lei, tem que pagar!”
Zita Souza Morais Silva comenta a postagem “Sindicato afirma que não pagamento de piso salarial é questão política e não financeira”
“A impressão que dá é que a empresa está aproveitando do dinheiro do povo. Antes, até dava para entender por conta da gasolina, mas agora não tem justificativa para esse preço exorbitante”
Cauã Souza, sobre a matéria “Além de salário dos motoristas, empresas de ônibus de BH precisam melhorar veículos”
“Coisa linda gente, isso é maravilhoso!”
Ana Karla, sobre a matéria “Prefeitura convoca capoeiristas para pesquisa sobre a prática, que pode virar patrimônio de BH”
ENTREVISTA
ZEMA BUSCAR HERDAR LIDERANÇA DE EXTREMA DIREITA
Com a derrota de Bolsonaro, o governador mineiro Romeu Zema Novo, aliado do ex-presidente, tenta se realocar frente ao governo Lula. Confuso entre como se manter antagonista à esquerda e ao mesmo tempo tirar partido do novo cenário eleitoral, Zema ainda tenta achar o tom do seu segundo mandato.
Essa é a opinião do professor de ciência política da Universidade Federal de Minas Gerais (UFMG), Bruno Reis. Confira trecho da entrevista.
Brasil de Fato MG - Os ataques de Romeu Zema (Novo) a Lula (PT) foram retomados. Como avalia essa relação?
A oscilação recente do Zema dá impressão de que ele está buscando ainda a linha a seguir. Ele parece estar tateando, experimentando. Caso Bolsonaro fique em situação política muito fragilizada, Zema vai buscar ser seu herdeiro na liderança da direita. Neste momento, tem muita gente disputando essa posição, e isso obriga ele a exercer certa antagonização com o governo Lula. Mas isso é uma tarefa politicamente mais difícil, que requer
mais tarimba, mais tirocínio, sutileza estratégica e respaldo político, certa blindagem e organização que ele não parece ter montado ainda.

Como você projeta a relação do executivo federal e o legislativo mineiro nesses próximos anos, tendo políticos conservadoras no Congresso?
Essas figuras mais radicalizadas não vão estar exatamente à frente do Congresso nos próximos quatro anos, vão estar no Congresso. Alguns desses protagonistas são inteiramente constituídos em cima de um tom desrespeitoso e intolerante com o adversário.
Eles não fazem propriamente política, eles não estão lá em busca de compromissos mútuos, como é obrigação da representação política. Eles fazem apenas a mera confrontação, antagonização, desqualificação autoritária e intolerante de adversários. É disso que eles vivem.
Você vislumbra um enfraquecimento ou desgaste da gestão de Romeu Zema diante do governo Lula?
A ascensão do Lula à Presidência da República é um mega revés para a direita. Então o rumo que essa direita vai tomar é uma incógnita. O Zema é o candidato a tentar liderar essa direita, como governador eleito de Minas Gerais. Agora, não o vejo muito forte nesse papel. Vamos ver como evolui a economia para ver como as coisas vão se passar. As eleições para prefeitos em 2024 também vão nos ajudar a traçar melhor como será a situação em 2026.
PÁGINA: www.brasildefatomg.com.br
O jornal Brasil de Fato circula semanalmente com edições regionais, em Minas Gerais, no Rio de Janeiro, no Paraná e em Pernambuco. Queremos contribuir no debate de ideias e na análise dos fatos do ponto de vista da necessidade de mudanças sociais em nosso país e no nosso estado.
CORREIO: redacaomg@brasildefato.com.br
PARA ANUNCIAR: publicidademg@brasildefato.com.br
TELEFONES: 31 9 8468-4731 e 31 9 8888-1817
conselho editorial minas gerais: Aruanã Leonne, Beatriz Cerqueira, Bernadete Esperança, Bruno Pedralva, Ênio Bohnenberger, Felipe Pinheiro, Frederico Santana Rick, Helberth Ávila de Souza, Jairo Nogueira Filho, Jefferson Leandro, Joana Tavares, João Paulo Cunha (in memorian), Joceli Andrioli, Jô Moraes, José Guilherme Castro, José
Quadros,
Marcelo
Makota Celinha, Maria Júlia Gomes de Andrade, Milton Bicalho, Neila Batista, Nilmário Miranda, Padre Henrique Moura, Padre João, Pereira da Viola, Renan Santos, Robson Sávio, Rogério Correia, Samuel da Silva, Talles Lopes, Titane, Valquíria Assis, Wagner Xavier. Edição Geral: Larissa Costa (Mtb 22066/MG) Subedição: Amélia Gomes, Elis Almeida,
OPINIÃO 2
Luiz
Juarez Guimarães,
Almeida,
Frederico Santana, Rafaella Dotta e Wallace Oliveira Redação: Amélia Gomes, Ana Carolina Vasconcelos, Rafaella Dotta e Wallace Oliveira. Colaboração: André Fidusi, Anna Carolina Azevedo, Diego Silveira, Joana Tavares. Administração e distribuição: Luiz Paulo Macedo Alves e Vinícius Moreno Nolasco. Diagramação: Tiago de Macedo Rodrigues. Revisão
Luciana Gonçalves Tiragem: 20 mil exemplares. Razão social: Associação Henfil Educação e Comunicação
Belo Horizonte, 27 de janeiro a 2 de fevereiro de 2023
Antagonização, desqualificação autoritária e intolerante de adversários. É disso que eles vivem.
Declaração da Semana
Números da Semana
30 mil
Indígenas vivem na terra indígena. Yanomami, em Roraima. Desde que o governo federal enviou técnicos do Ministério da Saúde à região, diversas denúncias de violações de direitos humanos estão sendo registradas, sobretudo com a ação do garimpo ilegal. Leia mais na página 8
Cursos gratuitos

Até o dia 10 de fevereiro, estão abertas as inscrições para os cursos gratuitos de porteiro com informática, culinária afro-brasileira e modelagem ofertados pela Prefeitura de Belo Horizonte. As inscrições podem ser realizadas on-line ou presencialmente no Sine Barreiro, Sine Venda Nova e no BH Resolve. Ao todo, são 21 vagas e a seleção será feita por meio de uma avaliação socioeconômica dos candidatos. Os cursos estão previstos para começar em 27 de fevereiro e vão até 24 de março. Mais informações, em prefeitura.pbh.gov.br.


Você conhece a guariroba?
Guariroba, catolé, pati, jaguaroba, ou somente gueroba. O nome pode até variar, mas a planta é rica em nutrientes e famosa pelo palmito de textura firme e de gosto amargo. Ele é consumido em conserva, saladas, refogados e pode se transformar em ótimos recheios para tortas e empadões. Além do palmito, a guariroba rende cocos, de onde se extraem amêndoas. A bela palmeira da gueroba é usada até no paisagismo de praças e parques.

GERAL 3 Belo Horizonte, 27 de janeiro a 2 de fevereiro de 2023
Rita Lobo, chefe de cozinha.
Divulgação Reprodução Reprodução
“Hoje só tem um lado: dos Yanomamis. Comida de verdade é vida. Mas não só pra minha família, ou só pra sua. É pra todos. Comida de verdade é um direito de todos os brasileiros”
Horta comunitária garante alimentos saudáveis e fonte de renda para mulheres em Contagem
AGRICULTURA URBANA Projeto, que revitalizou terreno abandonado, é subsidiado pela prefeitura e organizado por moradoras
Janine Moraes/PMC
Amélia Gomes
O que antes era um terreno baldio, que oferecia perigo aos moradores do bairro Sapucaias, em Contagem, na Região Metropolitana de Belo Horizonte, hoje produz alimentos saudáveis para dezenas de famílias. Desde 2022, 26 mulheres da comunidade se organizaram para solicitar à prefeitura a utilização de uma área pública, que estava sem destinação.

No terreno, de 3 mil metros quadrados, as moradoras produzem hortaliças, verduras, legumes, e cultivam plantas medicinais e ornamentais. Neste mês, o
espaço receberá apoio material para a construção coletiva de um espaço de convivência, onde a comunidade poderá organizar reuniões e otimizar as atividades na horta.
A porteira escolar Alva Rodrigues é uma das responsáveis pelo projeto. Ela explica que, no local, há espaços de produção coletiva e canteiros individuais, em que cada voluntária pode plan-
tar o que preferir. Moradora de apartamento, Alva nunca teve um contato mais próximo com a terra. Para ela, a experiência tem sido terapêutica.
Além disso, com o seu canteiro, ela consegue fornecer produtos para fami-
liares e amigos, alimentando até três famílias. “Economicamente falando é maravilhoso. Ajuda muito, porque está tudo muito caro. E a gente tem hortaliças e legumes colhidos em casa. Tudo sem agrotóxico, fresquinho”, aponta.
Política pública
Além do terreno e da infraestrutura, a Prefeitura de Contagem também fornece às voluntárias da horta formação e qualificação sobre agricultura e agroecologia.
Ao todo, são 45 unidades produtivas em Contagem, entre hortas comunitárias, institucionais e unidades de produção da agricultura familiar.
Prefeitura convoca capoeiristas para pesquisa sobre a prática, que pode virar patrimônio de BH
Horizonte, é um dos articuladores da iniciativa. Ele espera que, além do reconhecimento como patrimônio, o levantamento se desdobre em benefícios ao setor, como a criação de um espaço coletivo destinado à capoeira em BH.
O levantamento já apontou a existência de 26 mestres na cidade e 64 grupos
“Um espaço onde nós possamos nos encontrar, fazer eventos e continuar discutindo políticas para a categoria. A gente precisa desse espaço, é uma reivindicação antiga do nosso povo”, anseia.

Amélia Gomes
Para conhecer melhor a capoeira em Belo Horizonte, a prefeitura realiza um mapeamento do setor. O objetivo da pesquisa é contribuir para fortalecer a prática na cidade e coletar informações para o pedido de registro da capoeira como patrimônio imaterial da capital.

Até o momento, o levantamento, realizado desde 2021, apontou a existência de 26 mestres na cidade, sendo duas mulheres, 64 grupos de capoeira e 350 participantes. Mas a estimativa é que os números sejam muito maiores. Por isso, o levantamento segue aberto.
Mestre Primo, membro do Fórum da Capoeira de Belo
4 CIDADES Belo Horizonte, 27 de janeiro a 2 de fevereiro de 2023
Lecy Almeida
ANÚNCIO
No local, há espaços de produção coletiva e canteiros individuais, em que cada voluntária pode plantar o que preferir
Serra da Serpentina: Vale quer fazer captação de água gigantesca em afluente do Rio Doce
CONTRAMÃO Mineradora pretende construir mineroduto de 107 quilômetros, que atravessa 11 municípios e duas bacias hidrográficas
Rafaella Dotta
Está em análise mais um empreendimento da empresa Vale S.A. para Minas Gerais. O projeto Serra da Serpentina pretende explorar minério de ferro e se instalar nas regiões Norte e Nordeste do estado, atravessando 11 municípios.
Além de cavas e uma usina de tratamento, o complexo terá um mineroduto de 107 quilômetros, que irá de Conceição do Mato Dentro a Nova Era. A estrutura atravessa duas bacias hidrográficas, a do Rio Santo Antônio e a do Rio Piracicaba, e pode influenciar negativamente a recarga da bacia do Rio Doce.
Para operar o mineroduto, a empresa pretende usar a água do Rio Santo Antônio, na quantidade de 720 milhões de litros de água por mês. A informação é do Relatório de Impacto Ambiental (Rima) Serra da Serpentina, protocolado na Superintendência Regional de Meio Ambiente Jequitinhonha, em outubro de 2022.
O projeto da Vale ainda vai impactar diretamente 249 outorgas e usos d’água, hoje empregados por moradores e empresas locais para consumo humano, animal, industrial e abastecimento público, segundo dados do Rima.
Recuperação do Rio Doce está em jogo
A pretensão é vista como uma afronta pela bióloga e analista ambiental do Instituto Chico Mendes de Conservação da Biodiversida-
Profissionais da educação cobram que Romeu Zema pague piso salarial e reajustes atrasados
Projeto pretende utilizar 720 milhões de litros de água por mês

de (ICMBio) Beatriz Ribeiro. O Santo Antônio é um dos maiores e mais ricos afluentes do Rio Doce. Logo, segundo ela, o seu uso desmedido impactará sobremaneira a biota já tão danificada.
“Uma proposta como essa ignora o papel ecológico do Rio Santo Antônio para a recuperação ambiental do Rio Doce”, critica.
Em 2015, o Rio Doce foi impactado pelo rompimento da barragem de Fundão, da Samarco (propriedade da Vale e da BHP Billiton), que lançou 63 milhões de metros cúbicos de rejeitos de mineração no seu leito.
Região já sofre com maior mineroduto do mundo
Atualmente, o Rio Santo Antônio é impactado pelo
maior mineroduto do mundo, com 529 quilômetros de extensão, do projeto Minas-Rio, da mineradora Anglo American.
“A escassez hídrica do Rio do Peixe, afluente do Santo Antônio, onde é captada a água para o transporte do minério da Anglo American, é notória”, conta o presidente do Comitê da Bacia Hidrográfica Santo Antônio, Filipe Gaeta.
“Nesse rio, são retirados 2,5 mil metros cúbicos por hora, água suficiente para abastecer uma cidade de aproximadamente 200 mil habitantes”, ilustra.
O comitê ainda não foi comunicado formalmente, e deve atuar no momento do requerimento de outorgas de água. No entanto, Filipe já aponta uma série de irregularidades cometidas pela Vale, por exemplo, como as consultas previstas nas legislações municipais a conselhos ambientais, que não foram realizadas.
A reportagem procurou a Vale, mas não obteve resposta até a publicação desta matéria.
Redação
O Sindicato Único dos Trabalhadores em Educação de Minas Gerais (Sind-UTE/MG) realiza mais uma campanha de cobrança para que o governo mineiro, sob a gestão de Romeu Zema (Novo), pague aos professores e demais trabalhadores da Educação o Piso Salarial da Educação, estipulado por lei nacional.
Camilo Santana, ministro da Educação do governo Lula, anunciou na segunda (16) um reajuste de quase 15% no piso salarial nacional dos professores, que passa de R$ 3.845,63 para R$ 4.420,55. No entanto, em Minas Gerais, o vencimento básico do professor de educação básica, com carga horária de 24 horas, nível 1 e grau A, é de R$ 2.350,49.
Fora da Lei
Por meio de um ofício encaminhado no dia 2 de janeiro ao governador, o Sind-UTE/MG cobra o cumprimento da Lei Federal 11.738/2008, que instituiu o piso salarial em todo o país.
Denise Romano, coordenadora do Sind-UTE/MG, sustenta que o não pagamento do piso não é por questões financeiras, mas sim, políticas.
“Minas Gerais tem o recurso. O ano terminou com R$ 3,5 bilhões na conta do Fundeb [Fundo de Manutenção e Desenvolvimento da Educação Básica]. Esse recurso seria suficiente para pagar o reajuste do ano passado, quitar a dívida que o governo de Minas tem com a categoria nos anos anteriores, e o governo não quis”, argumenta.

MINAS 5 Belo Horizonte, 27 de janeiro a 2 de fevereiro de 2023
Mídia NINJA
Gil Leonardi /Imprensa MG
Brasil de Fato completa 20 anos de comunicação popular e luta pela democracia

ANIVERSÁRIO Lançado em 25 de janeiro de 2003, projeto completa duas décadas de contribuição para um Brasil mais justo
populares para a sociedade brasileira, disputando a interpretação dos fatos políticos com a mídia tradicional.
Um dos idealizadores do projeto, João Pedro Stedile, liderança do Movimento dos Trabalhadores Rurais Sem Terra (MST), conta que a ideia partiu de um “desafio histórico para as esquerdas e os movimentos populares, de que é necessário que tenhamos nossa própria voz, nossos meios de comunicação de massa, e não ficar apenas dependendo de veículos de outras classes, que transmitem suas visões de mundo”.
Hoje à frente da direção do projeto, a jornalista Nina Fideles entrou na comunicação do MST em 2003 como assessora de imprensa, e logo teve de enfrentar o complicado cenário da Comissão Parlamentar de Inquérito (CPI) da Terra. Criada com o argumento de discutir a estrutura fundiária brasileira e propor um modelo de reforma agrária para reduzir a violência no campo, a CPI se tornou palco de ataques virulentos de políticos ligados à bancada ruralista contra os movimentos do campo, em especial o MST.
Nicolau Soares
Era janeiro de 2003. O Brasil comemorava a primeira eleição de Luiz Inácio Lula da Silva (PT); na Argentina, Nestor Kirchner se preparava para conquistar seu primeiro mandato presidencial, na esteira do desastre econômico neoliberal. Na Bolívia, o movimento Al Socialismo de Evo Morales e seus cocaleros se fortaleciam em um país que, poucos meses depois, teria suas ruas tomadas por protestos contra a privatização do gás natural, no episódio que ficou conhecido como “A guerra do gás”. Os Estados Unidos pressionavam a comunidade internacional para apoiar a invasão ao Iraque, que se consumaria dois meses mais tarde.

Enquanto isso, em Porto Alegre (RS), 100 mil pessoas se reuniam para a terceira edi-
ção do Fórum Social Mundial, entre 23 e 28 de janeiro. Foi no sábado, dia 25, que 7 mil delas lotaram o Auditório Araújo Viana, no Parque Farroupilha, para um evento histórico: o lançamento do Brasil de Fato, iniciativa pioneira de jornalismo organizada por movimentos populares brasileiros.
A mesa de abertura mostra a importância do momento: lá estavam o escritor uruguaio Eduardo Galeano, a médica cubana Aleida Guevara, filha do Che, o linguista esta-
dunidense Noam Chomsky, a argentina Hebe de Bonafini, líder das Mães da Praça de Maio, o fotógrafo Sebastião Salgado e o teólogo Leonardo Boff, entre outros nomes da esquerda nacional e mundial. Primeiro editor a liderar o projeto, o jornalista e professor da Pontifícia Universidade Católica de São Paulo (PUC-SP) José Arbex se recorda da empolgação do dia. “Foi um negócio impressionante. Havia um entusiasmo de todo mundo”, lembra.
Perspectiva popular
A proposta era criar um jornal impresso, vendido em bancas, com distribuição nacional e tiragem de 100 mil exemplares para “competir com os jornalões”, nos termos de Arbex. Ou seja, um veículo popular e democrático, que levasse o ponto de vista da esquerda e dos movimentos
“É interessante porque é o mesmo período em que o Brasil de Fato é criado. E é interessante, porque acho que o jornal nasce das circunstâncias e demandas de o projeto popular ganhar mais visibilidade. E aí culmina com este momento histórico, a criação de um veículo que poderia dar visibilidade às pautas, disputar narrativas”, analisa.
6 Belo Horizonte, 27 de janeiro a 2 de fevereiro de 2023 REPORTAGEM ESPECIAL
A ideia, segundo Stedile, partiu do desafio dos movimentos de ter seus próprios meios de comunicação
Aleida Guevara e Noam Chomsky foram algumas personalidades presentes no lançamento do jornal
A liderança argentina Hebe de Bonafini lê a edição zero do Brasil de Fato
Leonardo Melgarejo
EDIÇÕES REGIONAIS IMPRESSAS EM NOVE ESTADOS
RETRANSMISSÃO EM 280 RÁDIOS DO PAÍS
CORRESPONDENTES FIXOS NA ARGENTINA, VENEZUELA, RÚSSIA, CUBA E EUA
O Brasil de Fato na atualidade
Entre falta de recursos e im passes políticos entre as for ças da esquerda, o projeto ori ginal foi se modificando. De diário, o jornal passou a ser semanal. Mais tarde, em 2013, mudou para tabloides produzidos regionalmente e distribuídos de forma gratuita.
Criou um portal que vem batendo recordes de audiência, chegando a superar 11 milhões de visualizações em um único mês em 2022. Incorporou a experiência do MST com rádio e hoje produz conteúdos que são retransmitidos por 280 rádios comunitárias e educativas em todo o país. Criou uma equipe para produção audiovisual, desenvolvendo programas próprios e parcerias com outras emissoras.
Desenvolveu canais nas principais redes sociais e produz conteúdos adaptados para múltiplas plataformas. Tudo isso sem abrir mão da proposta política de levar até a sociedade notícias sobre o cotidiano social e político brasileiro com o ponto de vista dos movimentos populares e da esquerda nacional.






Atualmente, edições regionais são editadas de forma independente por coletivos em nove estados: Bahia, Ceará,

SITE NACIONAL COM RECORDES DE AUDIÊNCIA
CONTEÚDO EXCLUSIVO PARA MÚLTIPLAS PLATAFORMAS
TRADUÇÃO PARA O INGLÊS E ESPANHOL
com outros países, com a tradução de seus conteúdos para inglês e espanhol. Para Nina, a questão da internacionalização sempre foi transversal à concepção do veículo.
Distrito Federal, Minas Gerais, Paraíba, Paraná, Pernambuco, Rio de Janeiro e Rio Grande do Sul. Cada estado possui equipe própria e seus próprios meios de financiamento, mas todos caminham dentro da linha editorial discutida ao longo dos anos dentro do projeto e com os movimentos populares.
Há correspondentes fixos na Argentina, Venezuela, Rússia, Cuba e Estados Unidos, além de parcerias com veículos de todos os continentes. E o projeto alcançou uma nova fase nessa relação
“Hoje, ela ganha uma outra proporção, que é a gente conseguir traduzir os acontecimentos no Brasil para fora. Eu acho que lá atrás a gente fazia um movimento de olhar o mundo. Por isso que o slogan é ‘uma visão popular do Brasil e do mundo’, a gente sempre valorizou isso. Só que hoje eu acho que ele ganhou essa proporção de como é que a gente disputa uma narrativa fora”, aponta.

Leia reportagem na íntegra. Aponte sua câmera para o QR code

7 Belo Horizonte, 27 de janeiro a 2 de fevereiro de 2023 REPORTAGEM ESPECIAL
José Arbex, primeiro editor do Brasil de Fato, durante o lançamento do jornal
Leonardo Melgarejo
Larissa Costa
Bolsonaro já cometeu inúmeros ataques contra indígenas; relembre
GENOCÍDIO Omissão foi generalizada e se espalhou por Funai, Ibama, Exército e Secretaria Especial de Saúde Indígena, diz MPF
Redação
As informações e imagens chocantes divulgadas a partir da Terra Indígena Yanomami, em Roraima, se tornaram símbolo da atuação do ex-presidente Jair Bolsonaro (PL) perante os povos indígenas do Brasil. Desde antes de se tornar presidente, ele demonstrou, por palavras, atos ou omissões, sua obsessão em destruir terras e pessoas dos povos originários.
A grave crise humanitária vivida pelos Yanomami foi minimizada por Bolsonaro. Ele chamou o caso de “farsa da esquerda”. Ele omitiu, porém, o número de mortes violentas de indígenas, que cresceu durante seu governo. A manifestação é só mais um episódio de desprezo do ex-presidente de extrema-direita aos povos originários. Confira abaixo outros.
Ódio na Hebraica
Em abril de 2017, ainda como pré-candidato, Bolsonaro foi à Hebraica, um clube ligado à comunidade judaica no Rio de Janeiro. Em discurso que repercutiu por ataques grosseiros a quilombolas, ele prometeu o que viria a cumprir: permitir a exploração de “riquezas” sob os territórios indígenas.

Subversão da função da Funai
Fundada em 1967 (durante a Ditadura Militar) para promover os direitos dos povos indígenas, a hoje Fundação Nacional dos Povos Indígenas, sob o governo de Bolsonaro, se transformou em uma máquina de destruição dos povos que deveria defender. As coorde-
nações foram loteadas para militares, sem interlocução com lideranças dos povos originários.
Negligência na pandemia
Nos momentos mais agudos da pandemia de covid-19, o governo Bolsonaro, negando a ciência, enviou cloroquina a terras indígenas. E, quando as vacinas ficaram disponíveis, o acesso a elas foi dificultado.
Demissão de Bruno Pereira
Quando foi assassinado junto ao jornalista britânico Dom Phillips, em 2022, o indigenista Bruno Pereira estava afastado da Funai. O motivo do afastamento, em 2019, foi, justamente, a ação dele ao combater o garimpo ilegal em terras Yanomami. Fora da Fundação, foi morto por pessoas ligadas à extração mineral irregular.
PF abre inquérito para apurar genocídio do povo Yanomami

MPF é acionado contra Bolsonaro e Damares
Mentiras para questionar o Marco Temporal
O uso de mentiras se tornou, na prática, uma política de governo de Bolsonaro. Mais de uma vez ele usou informações falsas para tentar forçar a aprovação da tese, que restringe a marcação de terras indígenas. Ele chegou a dizer que “não iria cumprir” eventual decisão do Supremo Tribunal Federal (STF), caso saísse derrotado no processo.
Contra o “Dia dos Povos Indígenas”
Em 2022, vetou que o “Dia do Índio” se tornasse, formalmente, o “Dia dos Povos Indígenas”. O veto à mudança foi derrubado.
A pedido do ministro da Justiça, Flávio Dino, a Polícia Federal (PF) determinou, dia 25, a abertura de um inquérito para apurar os crimes de omissão e genocídio na crise humanitária vivida pelo povo Yanomami. A Superintendência de Roraima do órgão ficará responsável pelas investigações.
O objetivo é chegar até possíveis financiadores e operadores do garimpo ilegal na Terra Indígena Yanomami. O ex-presidente Jair Bolsonaro (PL) aparece como maior culpado pela crise. Para o ministro Wellington Dias, do Ministério do Desenvolvimento Social, “a intenção era de sufocar, sem atendimento, essa população”. Alisson Marugal, procurador da República em Roraima, afirma que o governo “fez operações para não funcionar. De 400 pontos de garimpo, atuaram em apenas nove. O resultado: nenhum”.
A bancada do PSOL na Câmara dos Deputados acionou, dia 23, o Ministério Público Federal (MPF) contra o ex-presidente Jair Bolsonaro (PL), a ex-ministra da Mulher, Família e Direitos Humanos e senadora eleita Damares Alves (Republicanos) e o ex-presidente da Fundação Nacional do Índio (Funai) Marcelo Xavier por supostos crimes cometidos contra os indígenas yanomami.
“Damares pediu a Bolsonaro, em plena pandemia da covid-19, que vetasse leitos de UTI, água potável, materiais informativos e itens de higiene. É um genocídio planejado”, afirmou a deputada federal eleita Célia Xakriabá (PSOL-MG).
8 8 Belo Horizonte, 27 de janeiro a 2 de fevereiro de 2023 BRASIL
Divulgação / Força Aérea
Várias ações contribuíram para o extermínio indígena
ANÚNCIO
www.malvados.com.br
BATATAS COZIDAS E TOSTADAS COM MANTEIGA TEMPERADA
POR LETÍCIA MASSULA, DA COZINHA DA MATILDE
• Ingredientes
• Batatas
• Manteiga
• Salsinha laminada a gosto
• Sal e pimenta do reino a gosto
Modo de preparo
PALAVRAS CRUZADAS DIRETAS
www.coquetel.com.br

Chute com a parte exterior do pé (fut.)
Áreas separadas pelo estreito de Bering
Estenoses (?): podem gerar o AVC (Med.)




© Revistas COQUETEL


1. Lave bem as batatas e cozinhe em muita água e sal até ficar macia. Depois, escorra bem e reserve;
Espaço de encontro de artistas
Artista que desenha em muros
Cultura que influenciou o México Albert Einstein, físico
Bioma de regiões tropicais secas
"O (?) do Nibelungo", ópera de Wagner
2. Em uma tigela, misture a salsinha picada com a manteiga em temperatura ambiente. Acrescente o sal e a pimenta do reino. Reserve;
4. Aqueça uma frigideira grossa e, de preferência, antiaderente. Depois que estiver bem quente, coloque as batatas amassadas e deixe tostar dos dois lados;
Poema épico de Homero (Ant.) Expressão de alívio
Variedade de maçã cultivada na Bahia Guarda armado que vigia um posto
Sufixo de "filhote": diminutivo Carrasco
650, em romanos A pilha "palito"
Letra do símbolo do euro Tema de promessas de campanhas eleitorais
Haste dentária
Palhaço interpretado por Luís Ricardo
Marca de idade
São o maior grupo islâmico do Irã
Cidade próxima à Londrina, no Paraná
Assunto de aulas de Direito Progredir
(?) Taylor, atriz do seriado "The 100"

(?) loco: no lugar Átomo eletrizado
Otávio Augusto, ator brasileiro
Oduvaldo Vianna, teatrólogo paulistano
Mulher muito bonita (gíria) Ajuste acústico do aparelho do som
Apelido de "Sueli"
3. Depois que as batatas estiverem bem secas e frias, amasse-as com o punho, até ficarem achatadas, porém, inteiras, como se fossem “batatas ao murro”;

5. Antes de servir, adicione a manteiga temperada e espere derreter.
Desejos intensos
Aplicações; empregos Envoltório do tutano
Material dispensável na conexão "wireless"
Enfeite de fantasias
Nota (abrev.)
9
ANÚNCIO VARIEDADES 9 Belo Horizonte, 27 de janeiro a 2 de fevereiro de 2023
Separamos aqui uma combinação infalível para você conquistar o coração da sua parceira. Trata-se da junção entre limpeza e um bom jantar. Em outras palavras, a demonstração de afeto e cuidado. Pode ter certeza que é a melhor declaração!
Solução
BANCO 63 TR GC AR TE R IAI S IL ADA EV A AV UF AI V SE NT IN EL A DC LO TE IN AAA EL IZ A EL EI OA SE GU RANÇ A PI VO OM ÃN B OZO U SOS EL VO LU ME RU G A SP AI XI IT AS FI O ARA PO NG AS
2/in. 3/eva — íon. 4/pivô. 5/eliza. 6/savana — xiitas. 7/trivela. 9/arapongas — arteriais.
Freepick
CIÊNCIA, COISA BOA!
A LAMA DA VALE E AS BACTÉRIAS RESISTENTES A ANTIBIÓTICOS
Em 25 de janeiro de 2019, a barragem da mineradora Vale, em Brumadinho, rompeu. Um dos maiores crimes socioambientais do país teve início ali. Além das 272 vidas humanas perdidas, diversos danos ainda se perpetuam no ambiente e na população que vive ao longo da bacia do Rio Paraopeba e da represa de Três Marias.
Em estudo publicado neste mês na revista científica Science of the Total Environment, pesquisadores da UFRJ, UFRA, UENF e do Instituto Oswaldo Cruz afirmam que a contaminação do rio pela lama da barragem induziu ao desenvolvimento de uma nova microbiota na água, inclusive com o aumento da proliferação de bactérias resistentes a antibióticos. Microbiota é o conjunto de seres microscópicos que vive em um ambiente.
Antibióticos são medicamentos que usamos para combater infecções por bactérias em nosso organismo. Eles possuem alguma substância que afeta a célula bacteriana e causa a sua morte. Acontece que há bactérias que são mais e outras menos resistentes a essas substâncias.
Quanto mais usamos determinado medicamento, mais eliminamos as menos resistentes e mais deixamos vivas no meio as mais resistentes. O que exige que cada vez sejam desenvolvi-
térias mais resistentes na água do rio. A contaminação por metais, como ferro, manganês, chumbo e alumínio, criou um ambiente propício para o desenvolvimento desses microrganismos. Aquelas menos resistentes foram eliminadas pelos metais, e ficaram as mais resistentes no ambiente.
dos medicamentos mais fortes e com diferentes tipos de substâncias.
Esse é um grande problema de saúde pública hoje e que tende a se agravar nas próximas décadas. A cada ano, 700 mil pessoas morrem por infecções de bactérias resistentes a antibióticos.
Estima-se que até 2050 esse número pode chegar à casa dos 10 milhões.

O que o estudo citado mostrou é que os metais presentes na lama da barragem provavelmente cumpriram o papel de selecionar as bac-
Ao consumir a água do rio, vegetais irrigados por ela ou peixes provenientes da mesma, há o risco de se contaminar com alguma dessas bactérias resistentes a antibióticos. Se a pessoa infectada vier a adoecer, o tratamento será muito mais difícil e o risco de morte maior.
Por isso, após quatro anos, as comunidades atingidas ainda exigem que os responsáveis paguem pelo crime que cometeram e que a Vale garanta a reparação integral dos danos causados. É urgente um modelo de mineração que agrida menos o ambiente e que seja voltado à vida e ao desenvolvimento social, e não ao lucro de acionistas.
Um abraço e até a próxima!
14 ANÚNCIO
Renan Santos é professor de biologia da rede estadual de ensino de Minas Gerais
10 Belo Horizonte, 27 de janeiro a 2 de fevereiro de 2023 VARIEDADES
A contaminação induziu ao desenvolvimento de uma nova microbiota na água
BH, Contagem e Juiz de Fora sediam “Campanha de popularização do teatro e da dança”

CULTURA Até 12 de fevereiro, público tem acesso a peças infantis e adultas, de todos os gêneros, e espetáculos por R$ 20 Redação
A edição de 2023 da “Campanha de popularização do teatro e da dança” conta com mais de 112 peças e espetáculos. Além da capital, as cidades de Contagem e Juiz de Fora, na Zona da Mata, também sediam a programação. Há também apresentações pontuais, previstas em Ribeirão das Neves e em Divinópolis.
O evento, que começou no último dia 17 e segue até 12 de fevereiro, promove o acesso do público às produções artísticas mineiras a preços acessíveis, com bilhetes de até R$ 20. Os ingressos podem ser adquiridos pela internet ou nos postos de venda, mas precisam ser retirados com até quatro horas de antecedência do espetáculo.
Uma das peças em exibição é A obscena senhora H – paixão e obra de Hilda Hilst, que tem dramaturgia, direção, encenação e cenografia de Juarez Guimarães Dias, professor do Departamento de Comunicação Social da Universidade Federal de Minas Gerais. O espetáculo, que entrou em cartaz no Palácio das Artes na quinta (26), retrata a conturbada e violenta relação da escritora com seu parceiro e primo Wilson Hilst e chama a atenção do público para questões da contemporaneidade, como machismo e relações abusivas.
O link para aquisição de ingressos e informações sobre a programação completa da “Campanha de popularização do teatro e da dança” em cada cidade podem ser consultados em www.vaaoteatromg.com.br.
4 anos de Injustiça e Impunidade.
se esqueça de Brumadinho!
Quatro anos do Rompimento da barragem Mina Córrego do Feijão, da Mineradora Vale. Uma avalanche de rejeitos de minério que devastou a Bacia do Rio Paraopeba e o Lago de Três Marias, levou destruição a 26 municípios e mudou drasticamente a vida de milhares de pessoas. Conheça o trabalho da Assessoria Técnica Independente dos atingidos e atingidas.
RE PA RA ÇÃO
Para saber mais acompanhe nossas redes sociais. aedasmg.org aedasmg
14 ANÚNCIO CULTURA 11 Belo Horizonte, 27 de janeiro a 2 de fevereiro de 2023
Não
Adriana Porto/Divulgação
Copa Centenário
abre inscrições e terá equipes mistas
Redação
Estão abertas as inscrições para algumas categorias que disputarão a 25ª edição da Copa Centenário de futebol Amador Wadson Lima, realizada pela Prefeitura de Belo Horizonte.
Neste ano, pela primeira vez, meninos e meninas poderão jogar juntos. A novidade vale para a categoria sub-13, seguindo as nor-

mas da Confederação Brasileira de Futebol. A inscrição das equipes vai até o próximo dia 3 e a indicação dos atletas deve ser feita até o dia 13 de fevereiro.
Nesta etapa, estão abertas as inscrições para as ca-
Rodrigo Clemente
DECLARAÇÃO DA SEMANA
Divulgação / Curitiba
tegorias sub-13 mista (nascidos a partir de 2010); sub15 masculina (nascidos a partir de 2008) e sub-17 feminina (nascidas a partir de 2006). Mais informações, em https://www.copacentenario.com.br/
O Palmeiras é bicampeão da Copa São Paulo de Futebol Jr.! O Verdãozinho derrotou o América mineiro por 2x1, no estádio do Canindé, em São Paulo, na quarta-feira (25), e cada vez mais demonstra que as categorias de base do clube são um celeiro de craques.


Gol contra
A Arena da Amazônia, estádio que recebeu a Copa do Mundo de 2014 em Manaus, teve o fornecimento de energia cortado, em função de dívida de R$ 39 milhões com a Amazonas Energia. Ainda assim, a data de início do Barezão segue marcada para o sábado (28), com a partida entre Nacional e Rio Negro. O estádio fará uso de gerador, caso necessário.
Coelhãozinho brilhou!
Carabobo e pendenga
“Estamos acostumados a ouvir o timbre masculino dominando as organizadas. Então, foi realmente de arrepiar sentir as mulheres ecoando suas vozes em todos os espaços do Couto Pereira”
Dia de estreia
Fabrício Farias
O time do sub-20 do América fez história em 2023! Quase três décadas após o título de 1996, chegou novamente a uma final da Copa São Paulo de Futebol Júnior, a maior competição da categoria do país, que neste ano reuniu 128 times de todos os estados. Embora tenha perdido a final para o poderosíssimo Palmeiras, o Coelhãozinho mostrou ao longo do campeonato muita organização, entrega, mentalidade vencedora e vários talentos individuais, como o goleiro Cássio, o volante Breno, o meia Adyson e os atacantes Luan e Renato. A base do América, que sempre foi vencedora e reveladora de talentos, tem melhorado e se profissionalizado ainda mais nos últimos anos.

Decacampeão
Para receber as matérias do BRASIL DE FATO MG diretamente no seu celular, envie uma mensagem para
É Galo doido!
A fase de testes de Eduardo Coudet no Atlético começou de forma sóbria. Vitória sem brilho, mas jogo emocionante com a defesa de pênalti de Everson. Como de hábito, houve sufoco. Nada anormal em início de temporada, em que o mais importante é a estreia na fase preliminar da Libertadores contra o – é quase impossível não rir – Carabobo, na Venezuela, dia 22 de fevereiro. Neste domingo tem o Tombense, no interior. Fora isso, causa estranheza o envolvimento do clube na pendenga do arquirrival com a Minas Arena, pois o Galo terá em pouco tempo uma arena à disposição. Agora, nosso maior palco para o futebol está se transformando em espaço para shows, eventos e até a quase fatídica tirolesa.
Salve, salve Nação Celeste! Sábado (28) é dia da nossa estreia em casa. E pelo visto, nossa casa mesmo, uma vez que Ronaldo não enxerga como possibilidade o Cruzeiro mandar os jogos no Mineirão. O mais impressionante de tudo é que, desde que a Minas Arena assumiu o controle do Mineirão, os times da capital têm se sentido prejudicados para mandarem, no gigante da Pampulha, seus jogos. É incrível a ausência de soluções em quase dez anos da nova gestão. Enquanto isso, vamos receber nosso time com novo uniforme e com uma nova vitória. Esse início de temporada é fundamental para que o time já vá adquirindo sua forma. Saudações celestes!
La Bestia Negra

15 ESPORTES 12 Belo Horizonte, 27 de janeiro a 2 de fevereiro de 2023
Juliana Fontes, jornalista, que fez a cobertura do jogo entre Coritiba e Aruko, no último dia 15, pelo Campeonato Paranaense, no qual a torcida foi formada exclusivamente de mulheres e crianças.
COELHÃOZINHO VICE DA COPINHA
Rogério Hilário
Bráulio Siffert
/brasildefatomg
31 98468-4731
Gol de placa